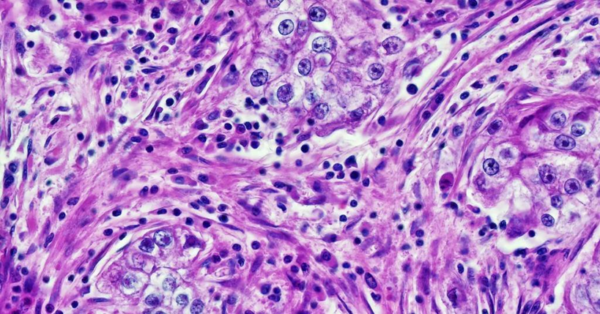
เมื่ออัลกอริทึมวินิจฉัยมะเร็งเริ่ม “เดาเชื้อชาติ” ของผู้ป่วย

Admin

2025, 12, 22
AI Re-News
OpenAI เปิดตัว ChatGPT Images เวอร์ชันใหม่ อัปเกรดโมเดลสร้างภาพเร็วขึ้น 4 เท่า พร้อมฟีเจอร์แก้ไขภาพแม่นยำ
สำนักข่าวบริคอินโฟ – โอเพนเอไอ (OpenAI) ประกาศเปิดตัว ChatGPT Images เวอร์ชันใหม่ล่าสุดอย่างเป็นทางการ โดยขับเคลื่อนด้วยโมเดลการสร้างภาพรุ่นเรือธงตัวใหม่ที่เน้นความเร็วในการประมวลผลสูงกว่าเดิมถึง 4 เท่า พร้อมเพิ่มความสามารถในการแก้ไขภาพ (Image Editing) ได้อย่างแม่นยำโดยยังคงรายละเอียดสำคัญของภาพต้นฉบับไว้ได้อย่างครบถ้วน

2025, 12, 22
AiNextopia News
เมื่อ AI กลายเป็นผู้คัดเลือกคนทำงาน
การหางานในปี 2025 ไม่ได้เป็นเพียงการเตรียมเรซูเม่หรือซ้อมตอบคำถามยอดฮิตอีกต่อไป แต่เป็นการเรียนรู้วิธี “สื่อสารกับอัลกอริทึม” ที่กำลังเข้ามามีบทบาทในทุกขั้นตอนของการจ้างงาน

Google Titans ก้าวกระโดดครั้งใหญ่ของ AI ที่เปลี่ยนอนาคตการจดจำและการเรียนรู้
ในโลกที่เทคโนโลยีปัญญาประดิษฐ์ (AI) กำลังพัฒนาอย่างรวดเร็ว สิ่งที่ผู้คนตั้งคำถามมาโดยตลอดคือ “AI จะสามารถจดจำและเรียนรู้ได้เหมือนมนุษย์จริงหรือไม่” คำตอบล่าสุดจาก Google Research คือการเปิดตัวสถาปัตยกรรมใหม่ที่ชื่อว่า Titans ซึ่งถูกออกแบบมาเพื่อแก้ปัญหาที่ฝังรากลึกในวงการ AI นั่นคือการขาดความสามารถในการจดจำระยะยาวและการเรียนรู้ต่อเนื่องในระหว่างการทำงานจริง

2025, 12, 21
AI-Essence, AiNextopia News
เบื้องหลังการเก็บข้อมูลครั้งใหญ่ของโลกแชตบอต เมื่อบทสนทนาลับกับ AI ไม่ได้ลับอย่างที่คิด
นักวิจัยด้านความปลอดภัยไซเบอร์ในเทลอาวีฟพบสิ่งผิดปกติบางอย่างในส่วนลึกของโค้ดโปรแกรมที่ผู้ใช้หลายล้านคนติดตั้งไว้โดยไม่คิดอะไรมาก มันคือส่วนขยายบน Chrome ที่ชื่อว่า Urban VPN Proxy เครื่องมือฟรีที่หลายคนใช้เพื่อปกปิดตัวตนบนโลกออนไลน์ แต่แทนที่จะเป็นเกราะป้องกันความเป็นส่วนตัว มันกลับทำหน้าที่ตรงกันข้ามอย่างน่าตกใจ

2025, 12, 21
AI-Essence, AiNextopia News, Highlight
SynthID และสงครามใหม่ของความจริงในยุค AI
ในช่วงไม่กี่ปีที่ผ่านมา โลกได้ก้าวเข้าสู่ยุคที่ภาพถ่ายไม่ได้เป็นหลักฐานของความจริงอีกต่อไป ภาพที่สร้างด้วยปัญญาประดิษฐ์มีความสมจริงจนแทบแยกไม่ออกจากภาพถ่ายจริง ความเปลี่ยนแปลงนี้นำมาซึ่งทั้งความตื่นเต้นและความหวาดหวั่น เพราะแม้เทคโนโลยีจะเปิดประตูสู่ความคิดสร้างสรรค์อย่างไร้ขอบเขต แต่ก็สร้างรอยร้าวครั้งใหญ่ให้กับความไว้วางใจของสังคมต่อสิ่งที่เห็นด้วยตา
2025, 12, 21
AiNextopia News
เมื่ออัลกอริทึมวินิจฉัยมะเร็งเริ่ม “เดาเชื้อชาติ” ของผู้ป่วย
ในห้องทดลองที่เต็มไปด้วยเสียงพัดลมของเครื่องคอมพิวเตอร์และแสงสีฟ้าจากจอภาพ นักวิจัยด้านรังสีวิทยากลุ่มหนึ่งกำลังจ้องมองผลลัพธ์ที่ไม่มีใครคาดคิดมาก่อน ระบบ AI ที่ถูกฝึกให้ตรวจจับมะเร็งจากภาพเอกซเรย์ กลับสามารถ “ระบุเชื้อชาติของผู้ป่วย” ได้อย่างแม่นยำ แม้ข้อมูลดังกล่าวจะไม่เคยถูกป้อนให้มันรู้ตั้งแต่แรกก็ตาม

2025, 12, 20
AiNextopia Article, Highlight
Mega Prompt เคล็ดลับการคุยกับ AI ให้ได้งานเทพ
หลายคนที่เริ่มใช้ AI ไม่ว่าจะเป็น ChatGPT, Gemini หรือ Claude มักจะเจอปัญหาเดียวกันคือ "ทำไมมันตอบไม่ตรงใจ?" หรือ "ทำไมคำตอบมันดูห้วนๆ ทั่วไปจัง?" สาเหตุส่วนใหญ่ไม่ได้มาจาก AI ไม่เก่งครับ แต่มาจากเรา "สั่งงานไม่ละเอียดพอ"

2025, 12, 20
AI Re-News
อาชีพแรกๆ ในธุรกิจมหาวิทยาลัยที่ถูก AI ดิสรัปท์ไม่ใช่ “อาจารย์”
ตลาดแรงงานในระบบนิเวศอุดมศึกษาทั่วโลกนั้น ขึ้นชื่อเรื่องความเสี่ยงและเปราะบางมากว่า 2 ทศวรรษ โดยเฉพาะยุคที่ต้องเผชิญกับปัญหาสังคมสูงวัย อัตราการเกิดลดต่ำลงอย่างมีนัยสำคัญ

2025, 12, 20
AI Re-News
AI อ่านสุขภาพข้าว! แค่ถ่ายรูปก็รู้ว่าข้าวแตกหน่อดีไหม ช่วยประเมินผลผลิตได้ทันที แม่นยำ 94–98%
การปลูกข้าวให้ได้ผลผลิตดี ไม่ได้ขึ้นอยู่แค่พันธุ์หรือปุ๋ย แต่ยังขึ้นกับ “ลักษณะของต้นข้าว” โดยเฉพาะ จำนวนหน่อ และลักษณะการรวมตัวของกอข้าว ซึ่งเป็นตัวกำหนดว่าข้าวจะแตกกอดี รวงหนาหรือบาง และจะส่งผลต่อผลผลิตโดยตรง

2025, 12, 20
AI Re-News
เปิดรายงาน Meta ครึ่งปี 68 ลบเนื้อหาหลอกลวงในไทยกว่า 7.3 ล้านชิ้น
Meta ยักษ์ใหญ่โซเชียลมีเดีย เผยรายงานสถานการณ์ภัยคุกคามล่าสุด ครึ่งปีแรก เดินหน้า กวาดล้างมิจฉาชีพ ครั้งใหญ่ในภูมิภาคเอเชียแปซิฟิกและประเทศไทย โดยสามารถสกัดกั้นเครือข่ายอาชญากรรมข้ามชาติและ มิจฉาชีพออนไลน์
